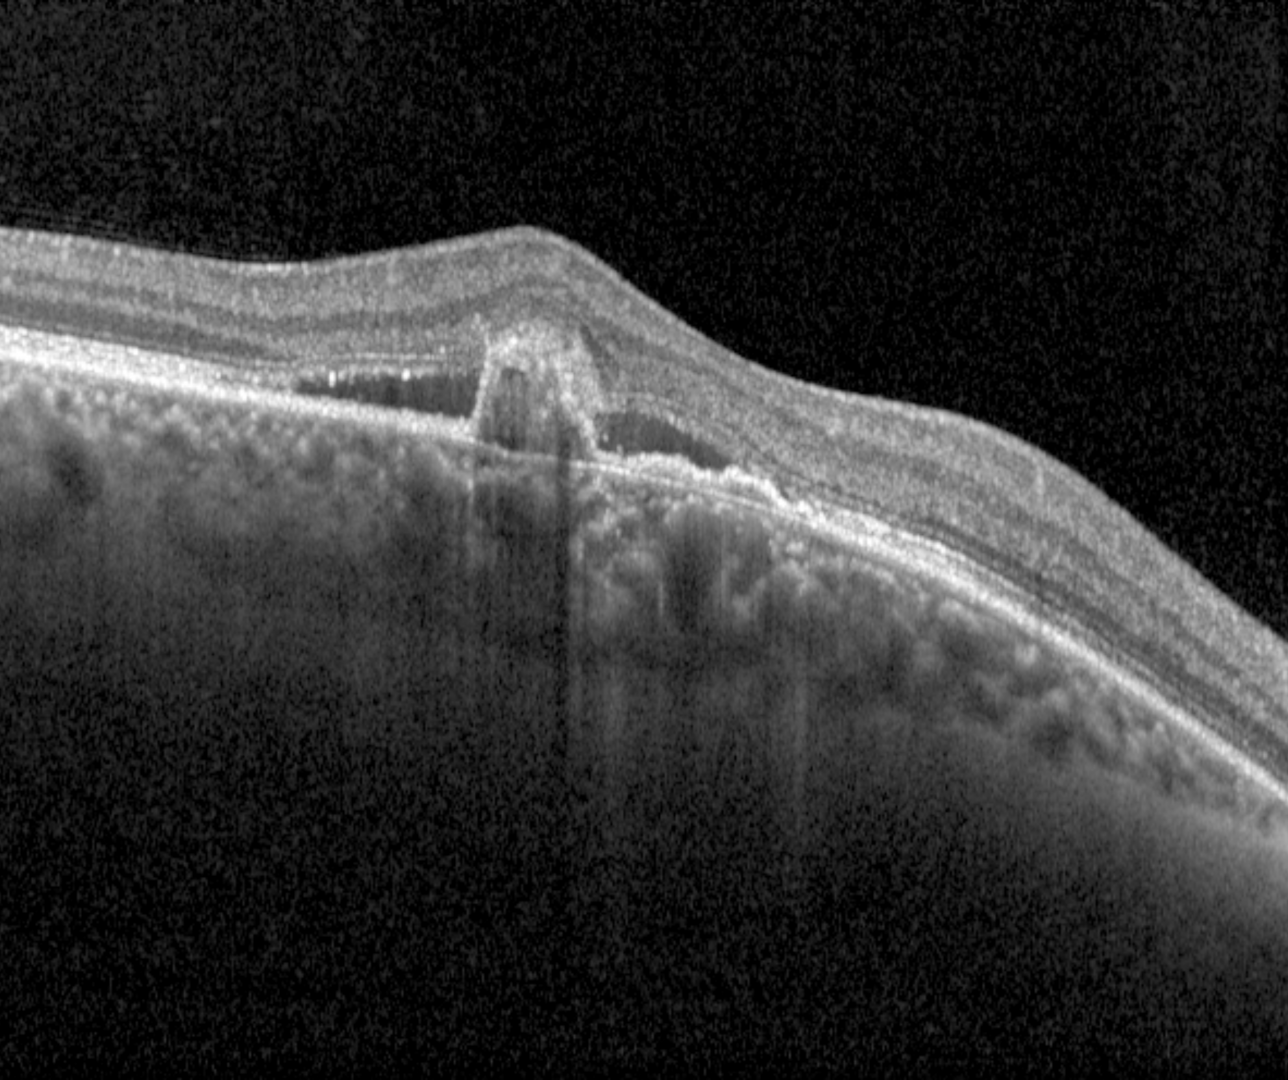

Overview
PCV, also known as aneurysmal type 1 neovascularisation, is characterised by the presence of orange nodular lesions arising from the choroidal neovascular network in the sub-RPE space. These nodular lesions are referred to as polypoidal lesions and are best visualised using indocyanine green angiography (ICGA).
Fundus photography typically shows orange-red subretinal nodules and may be associated with exudates and/or haemorrhages.
OCT shows multilobular PEDs with the peaked, thumb-like or notched component corresponding to the polypoidal lesion and the flat irregular PED harbours the type 1 neovascularisation.
OCT angiography allows visualisation of the choroidal neovascular membrane which appears as a tangled network of flow signal. OCTA is inferior to ICGA in displaying polypoidal lesions partially because the slow blood flow in these lesions is below the instrument’s detection threshold.
Fundus autofluorescence of PCV may show hypo-autofluorescent centre surrounded by a ring of hyper-autofluorescence.
Case Examples
-
Case 1: Active PCV
A 49 year old South American male with best corrected visual acuity of 6/7.5+ (20/25+) in his right eye.
-
Case 2: Active PCV
A 75 year old Asian female with best corrected visual acuity of 6/19 (20/63) in the right eye. Testing with an Amsler grid revealed distortion in the superior right quadrant when viewed with the right eye.
-
Case 3: Active PCV with associated haemorrhage
An 86 year old Asian male with systemic hypertension and best corrected visual acuity of 6/30+ (20/100+) in the right eye. Testing with an Amsler grid showed generalised metamorphopsia in this eye. He has noticed a deterioration in his vision in this eye over the last 2 years.
-
Case 3: Inactive PCV
A 59 year old Asian female with best corrected visual acuity of 6/7.5- (20/25-) in the left eye. Testing with an Amsler grid revealed distortion nasal to fixation in the left eye.
-
Case 5: Non-exudative (quiescent) PCV over 5 year period
An 82 year old Asian female with controlled hypertension. Pinhole acuities OD 6/19 OS 6/12. Endothelial guttae and posterior subcapsular cataracts, nuclear sclerosis.
Differential Diagnosis
References
Borooah, S, Sim, P.Y, Phatak, S, Moraes, G, Wu, C.Y, Cheung, CMG., Pal, B, Bujarborua, D. (2020), Pachychoroid spectrum disease. Acta Ophthalmol.
Cheung, CMG, Lee, WK, Koizumi, H. et al. Pachychoroid disease. Eye 33, 14–33 (2019).
Cheung CMG, Lai TYY, Ruamviboonsuk P et al. Polypoidal Choroidal Vasculopathy: Definition, Pathogenesis, Diagnosis, and Management. Ophthalmology 2018; 125: 708-724.